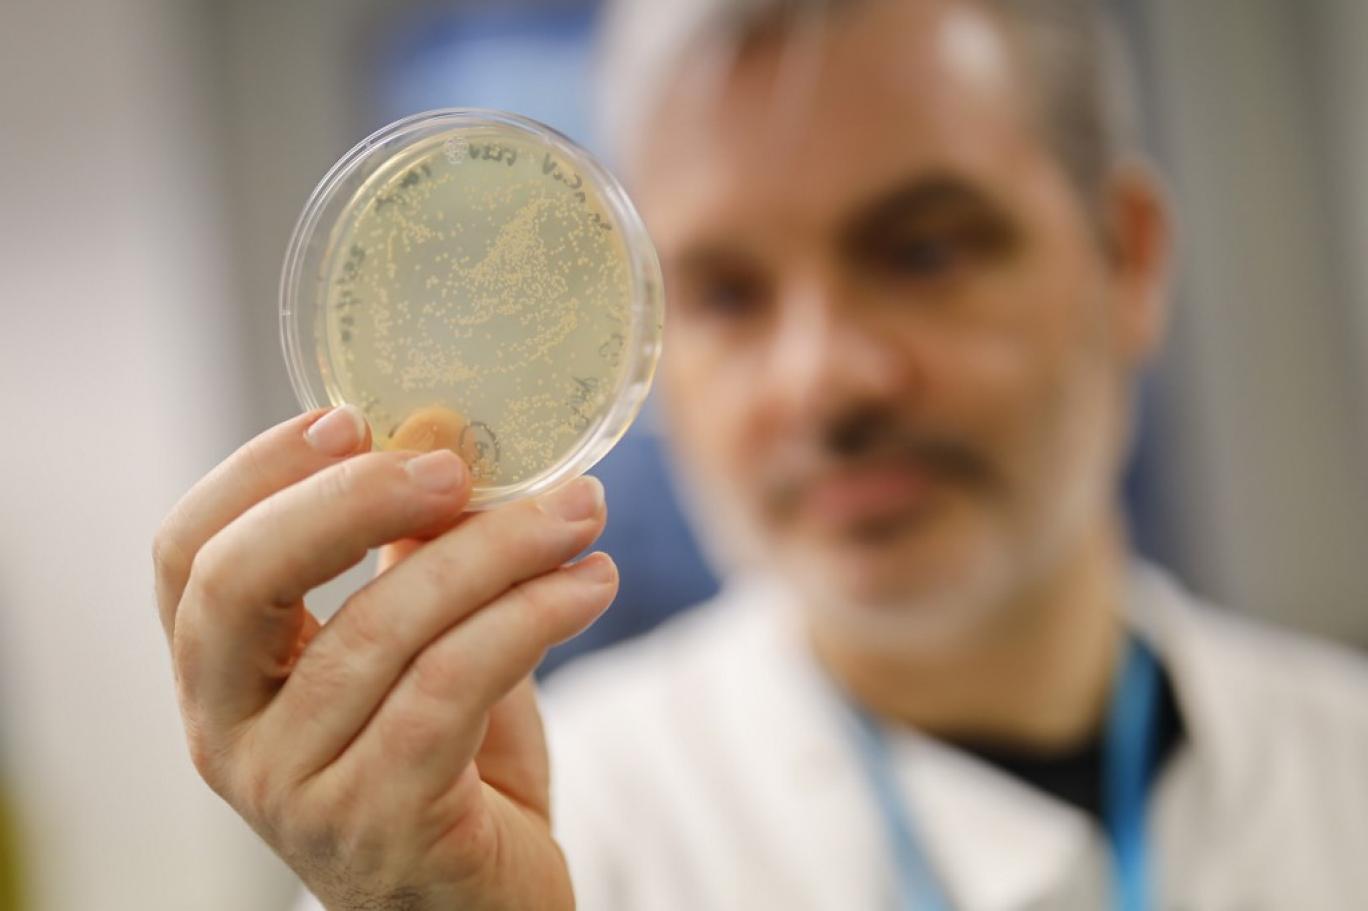

گروه علمی دانشگاه کوئینزلند، این هفته آزمایش واکسن کرونا بر حیوانات را آغاز میکند و امیدوار است که استفاده آزمایشی آن بر انسان تا نیمه سال جاری میلادی شروع شود.
پرفسور پال یانگ، سرپرست دانشکده شیمی و علوم زیستی مولکولی این موفقیت را در حالی اعلام کرده که شمار موارد شناسایی شده ابتلا به این ویروس در سطح جهان تقریبا به ۷۸ هزار نفر رسیده و ۲۳۵۵ نفر بر اثر آن جان باختهاند.
او گفت این گروه ۲۰ نفره برای تسریع روند کار، ۲۴ ساعته و در مدت سه هفته کار کرده تا یک پروتئین مهم در ویروس را شناسایی و بازسازی کند که مبنای واکسن بیماری است.
پتیر هوج، نایبرییس دانشگاه گفت: «هنوز آزمایشهای فراوانی باید انجام گیرد تا درباره ایمنی واکسن اطمینان و پاسخگویی موثر آن، اطمینان حاصل شود، اما تکنولوژی و ازخودگذشتگی پژوهشگران نشان میدهد که مانع اول پشت سر نهاده شده است.»
پرفسور یانگ روز شنبه در یک نشست خبری گفت: «این گروه وقتی آغاز به کار کرد که چین در اواخر ژانویه توالی ژنتیکی بیماری را اعلام کرد. این کار باعث شد ژنوم مورد نیاز ما را در اختیارمان گذاشت.»
او گفت: «دستاورد عمده در واقع تولید واکسن، قبل از مطالعه آن بر حیوانات است. ما اولین مطالعاتمان بر حیوانات را این هفته در دانشگاه کوئینزلند آغاز میکنیم.»
با آن که ۱۸ ماه طول میکشد تا واکسن آماده توزیع عمومی شود، اما به گفته پرفسور یانگ اگر ایمنی آزمایشهای بالینی اطمینانبخش باشد، این روند ممکن است تسریع شود.
هزینه کار پژوهشی این دانشمندان برای تولید سریع واکسن برای شیوع بیماریهای همهگیر را ائتلاف جهانی آمادگی اپیدمی میپردازد.
Read More
This section contains relevant reference points, placed in (Inner related node field)
تیم علمی فوق از تکنولوژی «تله مولکولی» استفاده میکنند تا به ایجاد پروتئینی کمک کنند که در واکسن به کار برده میشود. تیم علمی معتقد است که این روش باعث میشود احتمال شناختهشدن این که واکسن توسط سیستم ایمنی بدن افزایش یابد.
دکتر کیت چپل گفت: «ما برای تولید واکسن برخی از بزرگترین ویروسهای جهان مثل ایبولا، مرس، ویروس کرونا و نیپا از این تکنولوژی استفاده کردهایم. اما این تکنولوژی طوری طراحی شده تا بتواند به سرعت به یک ویروس ناشناخته نیز پاسخ سریع بدهد.»
او گفت: «ما با هدف کاش زمان لازم برای تولید واکسن از چندین سال به چند هفته، گروهی از موسسات دانشگاهی پیشرو در استرالیا را گرد هم آوردهایم.»
پرفسور یانگ گفت تلاشهای عمده متعددی برای تولید واکسن در جهان صورت گرفته که در بیشتر آنها از سریعترین اما کماثرترین روش توالی ژنی استفاده میشود تا ساختن پروتئین.
در نتیجه این وضع، به گفته این دانشمند، مشکل میشود گفت که آیا تلاش آنان اولین واکسن بالقوه تولیدی برای مقابله با ویروس کرونا است یا خیر. بیماری ناشی از ویروس کرونا، به شکل رسمی کووید-۱۹ خوانده میشود.
پرفسور یانگ گفت: «بهترین اتفاق ممکن، در حال حاضر در حال وقوع است و عبارت از این است که گروههای فراوانی برای تولید واکسن کار میکنند، و اولین گروهی که به این موفقیت برسد، کار فوقالعادهای کرده است. این مسابقه تولیدکنندگان واکسن نیست، بلکه مسابقهای است علیه یک ویروس خاص.»
او افزود: «این یک حوزه استحفاظی جدید در طراحی واکسن است. تولید واکسن از ایده اولیه تا مجوز و استفاده در میان جوامع، سالها طول میکشد. ولی هدف ما چیزی بین ۱۲ تا ۱۸ ماه است، که سرعت چشمگیری است.»
© The Independent